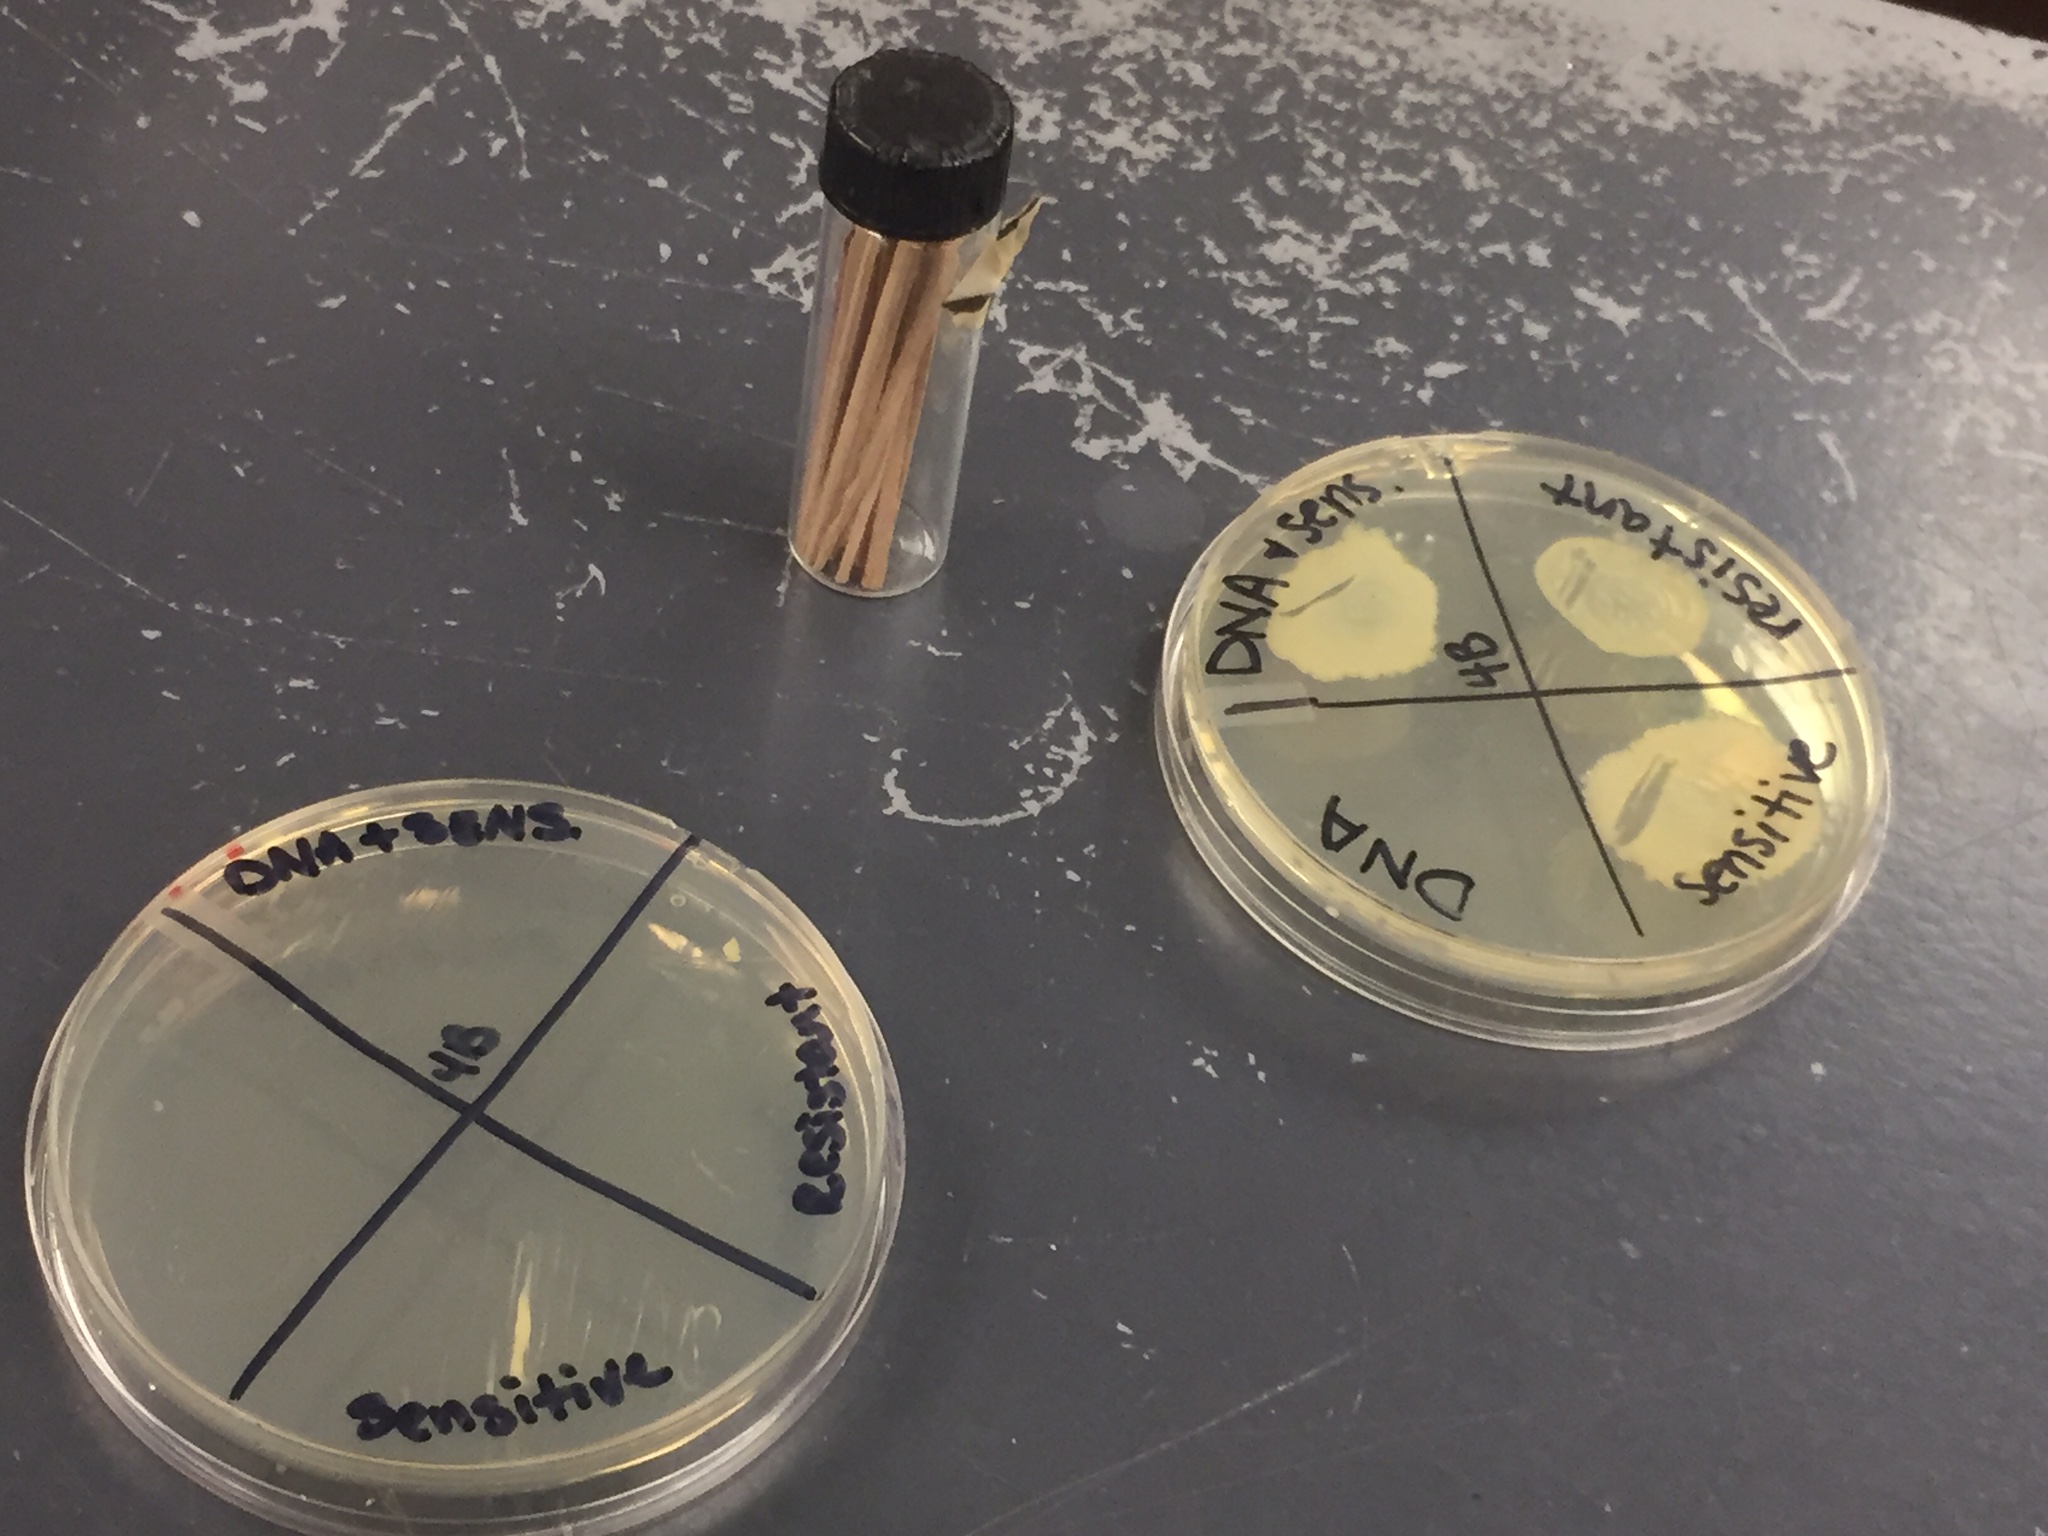
The hunt for bacteria is on

By Onaja Waki

Resistance to antibiotics is becoming stronger. In other words, our current antibiotics are not working as efficiently as they used to. To tackle this potential public health issue, various universities around the globe, including HSU, are participating in the Small World Initiative program.
According to the Small World Initiative website, the program aims to encourage students to pursue careers in science by conducting their own field and laboratory research through beginning college courses. Collectively, students contribute to the antibiotic resistance crisis and help complete the program’s mission, listed as, “crowdsourcing antibiotic discovery.”
This past fall semester and current spring semester, HSU biology majors in the microbiology option are required to work on this research project headed by microbiology and genetics professor Mark Wilson. Wilson’s biology 105 class requires students to search for bacteria in different environments around Arcata, such as in fungi or soil. The class’s findings will be sampled and tested and could possibly lead to new antibiotics.
“What we are doing is trying to isolate bacteria that we find then test it against strains that can stop the growth,” Wilson said. “We have began to look for bacteria in places like the redwood forest and the Arcata Marsh, because traditionally these places have not been searched. With doing so, we are hoping to find new organisms in our samples.”
This research project is approached in two ways. The first approach is to wait and observe to see if the bacteria stops growing when a given strain is tested against it. The second approach is to use the results from a separate biogeographical project.
“What biogeography means is how animals and plants are spread around the world,” said Wilson. “What this does is help to make decisions on if we should be looking for bacteria in other places in order to make antibiotics.”
Sophomore Tonie Alexander is currently in Wilson’s biology class and finds it useful to do the hands-on work and enjoys being apart of a large-scale research project.
“At first I was skeptical about how finding bacteria could be fun and interesting,” Alexander said. “But when I found out what we were really doing it for I found myself more than interested. It’s tedious work and it takes patience when testing our samples.”
Freshman microbiology emphasis major Nyla Hodge has yet to take Wilson’s class, but has heard a lot from peers about what the class requires.
“As of right now, I’m taking botany,” Hodge said. “But for next semester, I’m going to take biology 105, I just hope the labs aren’t hard. I know a few people who took the class already and they did a lot of field work. So I know I’ll have some real work to do.”
Wilson believes that this project is good for his “scientists-in-training” students and can also be an enjoyable experience.
“We started doing this because it was better for the students and I’m having fun doing it with them,” Wilson said.